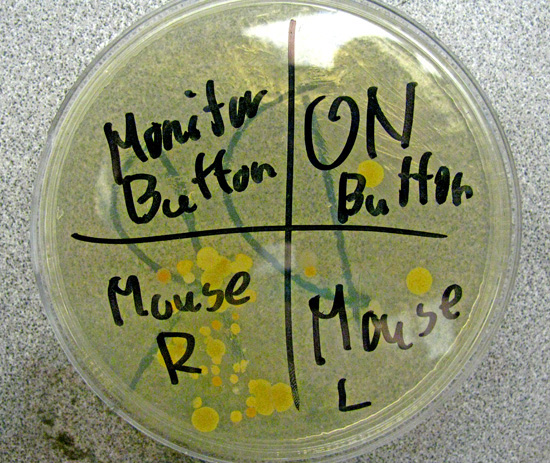

School
Weston, MA
Life Science Activities

Optical Illusions:
Magic Eye Illusions:
Other Illusions:

- Exploratorium: The Anatomy of Memory
- The Secret Life of the Brain: 3-D Brain Anatomy
- Sheep Brain Anatomy
- Mapping the Brain
- Edheads Deep Brain Stimulation Surgery,
- True Horror: Aldini
- In Search of Frankenstein
- Aldini at Newgate(article)


Youtube- Collecting Maple Syrup- Part 1
http://www.exploratorium.edu/cooking/bread/index.html

Edheads Virtual Hip Replacement Surgery, http://www.edheads.org/activities/hip/index.htm
Edheads Virtual Knee Replacement Surgery, http://www.edheads.org/activities/knee/index.htm
Growing Sprouts
Wheatgrass.com- Sprouting Supplies
- The Science of Seeds
- Parts of a Seed
- Chart- Monocots vs Dicots
- Video- Seed germination
- Watching Corn grow
- Investigating Seeds- Monocots vs Dicots
- Video: How to Sprout Seeds in a Paper Towel
- Video: Growing Mung Beans in a Paper Towel
- How to Grow Sprouts

Understanding the Science of Thanksgiving- NPR
Counting Bacteria Colonies
Titer of bacteria= # colonies counted x dilution x 1ml/vol(ml) of sample
Spreading Technique for Bacteria Counting

Kidney
Dissection
Kidney
Dissection

Revised March 2009 by Jonathan Dietz,
dietzj@mail.weston.org